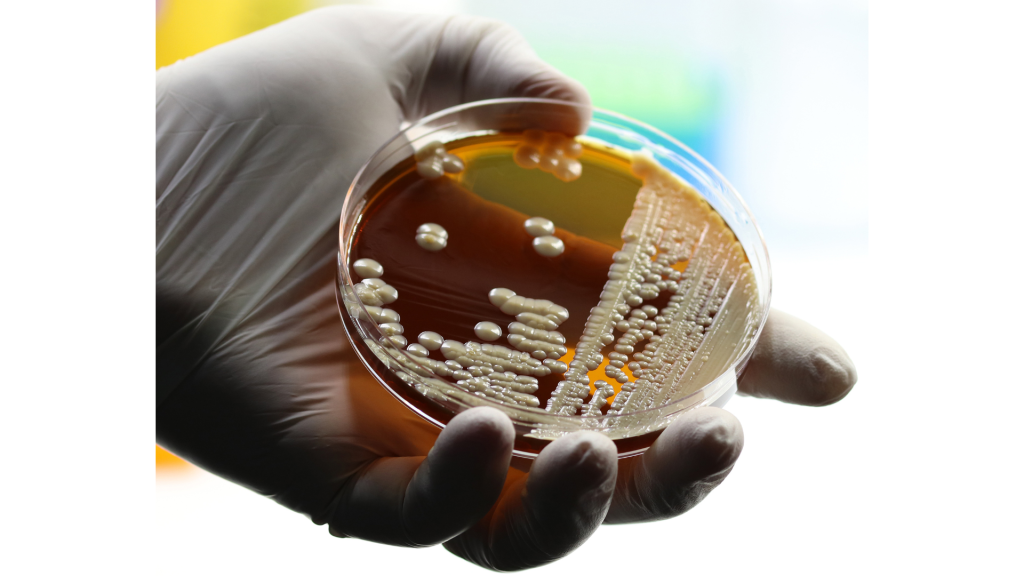
levaduras

La frutilla es uno de los frutos más apreciados por su sabor, aroma y versatilidad en la cocina, pero su corta vida útil ha sido históricamente un desafío para productores, exportadores y distribuidores. En pocos días, la fruta puede perder firmeza, color y frescura, lo que se traduce en pérdidas económicas significativas y en la imposibilidad de acceder a mercados lejanos.

En Chile, un equipo de investigadores está desarrollando una innovación que podría cambiar este escenario: el uso de levaduras nativas mejoradas para producir compuestos naturales capaces de retrasar la maduración y descomposición. Los primeros resultados ya muestran que esta tecnología puede prolongar la vida comercial de la fruta sin alterar su sabor ni sus características organolépticas.
Ensayos en San Pedro de Melipilla: resultados alentadores
La primera fase del proyecto se llevó a cabo en campo, en colaboración con agricultores de Agrofrutillas San Pedro, en la zona de San Pedro de Melipilla. Durante la temporada, se evaluó la efectividad de las levaduras nativas tanto en la fruta en planta como en postcosecha, midiendo parámetros clave como:
- Peso
- Firmeza
- Color
- Sanidad
- Vida útil
Los ensayos confirmaron que la aplicación de estas levaduras podía mantener la fruta en buen estado por más tiempo, reduciendo la incidencia de hongos y retrasando los procesos de senescencia, sin afectar el sabor ni la textura que los consumidores esperan.
Cómo funciona esta innovación
El sistema se basa en levaduras de la especie Saccharomyces cerevisiae, ampliamente conocidas por su uso en panificación y vinificación. En este caso, fueron aisladas de ambientes enológicos y sometidas a mejoramiento genético mediante cruzamientos convencionales para optimizar su capacidad de producir un gasotransmisor natural.
Este compuesto cumple dos funciones clave para la poscosecha de frutillas:
- Acción antimicrobiana: ayuda a prevenir el desarrollo de patógenos que deterioran la fruta.
- Regulación de la maduración: retrasa los procesos fisiológicos que llevan al ablandamiento y pérdida de color.
El director del proyecto, explica:
Trabajamos con levaduras aisladas y mejoradas para que produzcan un gas capaz de extender la vida comercial de la fruta. El objetivo es dar a los productores una herramienta biológica efectiva frente a las exigencias del mercado en fresco.– Dr. Sebastián Molinett Soto, investigador de INIA La Cruz
195 cepas en evaluación
El proyecto cuenta con un banco de 195 cepas de levaduras nativas frutillas seleccionadas por su capacidad de generar el gasotransmisor de interés. Durante la siguiente etapa, estas cepas serán sometidas a un programa de mejoramiento para identificar las que puedan producir la cantidad óptima de gas durante aproximadamente una semana, tiempo clave para el transporte y venta.
Este control de la tasa de producción es fundamental para asegurar que el tratamiento sea efectivo y seguro, sin generar efectos indeseados en la fruta.
💡 Te podría interesar
🍓 Ya Está Disponible el Programa Oficial de Conferencias de la Expo Fragaria Chile 2025
Aplicación práctica para productores
Para un productor de frutillas, el principal beneficio sería disponer de más días de vida útil desde la cosecha hasta el consumidor final. Esto permitiría:
- Enviar fruta a mercados más lejanos sin pérdidas significativas.
- Reducir el descarte de fruta por deterioro.
- Mantener estándares de calidad exigidos por clientes y exportadores.
- Ofrecer un producto más fresco y atractivo, aumentando la satisfacción del comprador.
Además, al tratarse de un sistema biológico, se alinea con la demanda creciente por productos más naturales y con menor carga de agroquímicos.
Colaboración y financiamiento
El proyecto es financiado por la Agencia Nacional de Investigación y Desarrollo (ANID), a través de su Subdirección de Investigación Aplicada (SIA). Lo lidera el Instituto de Investigaciones Agropecuarias (INIA) La Cruz, en colaboración con la Universidad de Santiago de Chile y la empresa AgroQ-Tral, que evalúa licenciar la tecnología para su futura comercialización.
El académico Claudio Martínez Fernández, PhD en Biología de la Universidad de Santiago, participa junto a su equipo en las evaluaciones bioquímicas y moleculares que permitirán seleccionar las cepas más prometedoras.
Siguiente fase: del campo al laboratorio
Concluida la primera temporada de pruebas en terreno, el trabajo continuará en laboratorio. Allí se realizarán análisis detallados para confirmar los resultados y ajustar las condiciones que maximicen el rendimiento de las levaduras nativas frutillas en distintos escenarios de almacenamiento y transporte.

También se explorará la factibilidad de integrar esta tecnología en los procesos actuales de poscosecha, buscando que su adopción sea sencilla y económicamente viable para productores de diferentes escalas.
Impacto esperado en un contexto de cambio climático
Las condiciones climáticas actuales tienden a acelerar la maduración y deterioro de la fruta. Esto obliga a buscar soluciones que no solo sean efectivas, sino también sostenibles y accesibles.
El uso de levaduras nativas frutillas podría convertirse en una herramienta clave para mitigar estos efectos, contribuyendo a:
- Reducir el desperdicio alimentario.
- Mejorar la rentabilidad de los productores.
- Facilitar el acceso a mercados internacionales exigentes.
- Promover una producción más sostenible y responsable.
Hacia una fruticultura más sustentable
Si los resultados de laboratorio confirman el potencial observado en campo, esta innovación podría estar disponible comercialmente en los próximos años. Productores, exportadores y asesores técnicos tendrían así una nueva alternativa biológica para mejorar la gestión poscosecha y adaptarse a las nuevas exigencias del mercado.
La combinación de ciencia aplicada, colaboración público-privada y un enfoque práctico orientado al productor posiciona a este proyecto como un ejemplo de cómo la investigación puede transformar la fruticultura chilena y latinoamericana.





















































